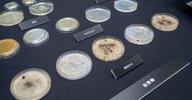
Image

記事一覧

微生物多様性を軸としたアート展示とFoodscapeの実践レポート in Thailand

微生物多様性を軸としたアート展示とFoodscapeの実践レポート in Thailand

ここ1年くらいの総括と記憶の整理

ここ1年くらいの総括と記憶の整理

微生物の多様性ってなに? #01

微生物の多様性ってなに? #01

ビジョナリーとはなにか? と決意表明

ビジョナリーとはなにか? と決意表明

赤城SUN doで微生物展示をしました
赤城SUN doで微生物展示をしました

微生物ワークショップ 『マイクローブ ハンティング』開催レポート
